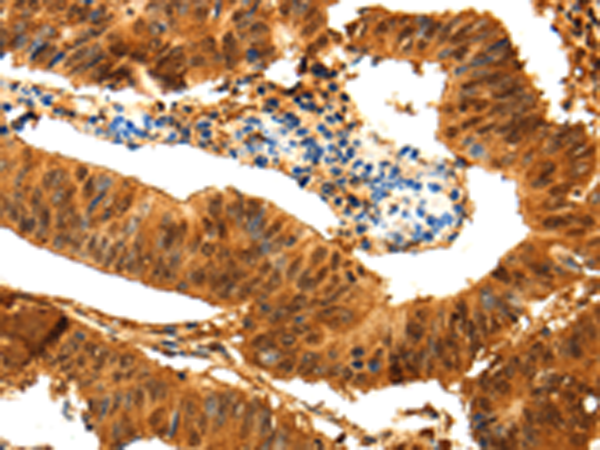
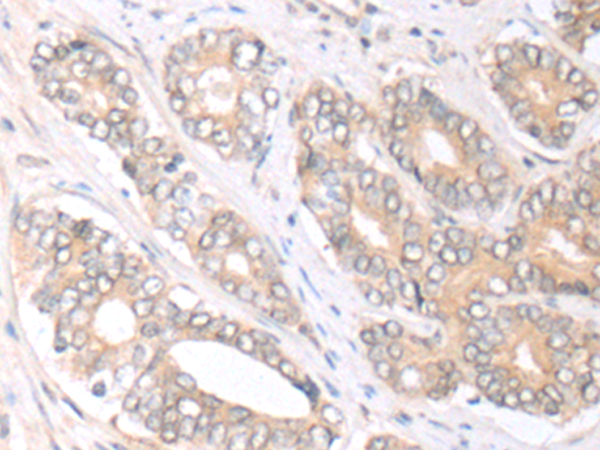
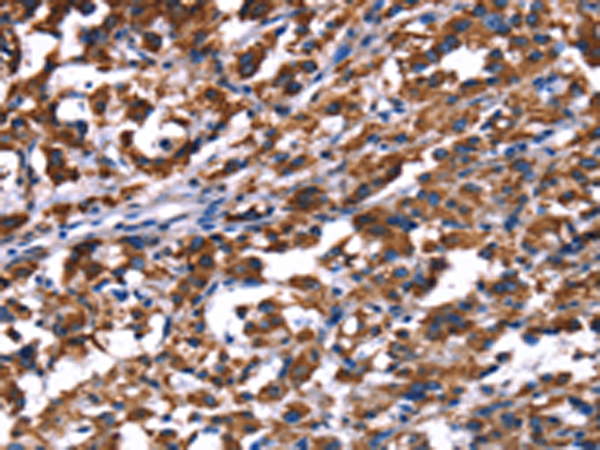
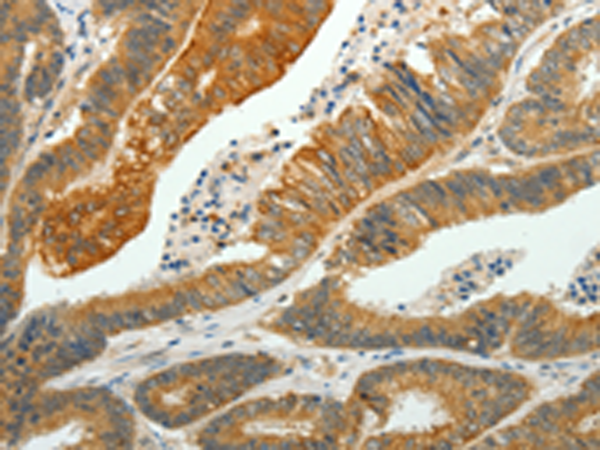

-
分类: 科研抗体货号: P00639别名: RAMP4应用: IHC反应种属: Human, Mouse, Rat
-
分类: 科研抗体货号: P00607别名: DJ1; DJ-1; HEL-S-67p应用: WB,IHC反应种属: Human, Mouse, Rat
-
分类: 科研抗体货号: P00635别名: PP-1B, PPP1CD, PP1beta应用: WB,IHC反应种属: Human, Mouse, Rat
-
分类: 科研抗体货号: P00602别名:应用: IHC反应种属: Human, Mouse
-
分类: 科研抗体货号: P00627别名: ZCHY; ARNIP; CHIMP; PIRH2; RNF199; ZNF363; PRO1996应用: WB,IHC反应种属: Human, Mouse
-
分类: 科研抗体货号: P00695别名: CIS4; SSI4; CIS-4; SOCS4; STAI4; SOCS-4; SOCS-6; STATI4; HSPC060应用: WB,IHC反应种属: Human, Mouse
-
分类: 科研抗体货号: P00626别名: PHB1应用: WB,IHC反应种属: Human, Mouse, Rat
-
分类: 科研抗体货号: P00680别名: HCP; HCPH; SHP1; SHP-1; HPTP1C; PTP-1C; SHP-1L; SH-PTP1应用: WB,IHC反应种属: Human, Mouse, Rat
-
分类: 科研抗体货号: P00622别名: NEF4; PRPH1应用: WB,IHC反应种属: Human, Mouse, Rat
-
分类: 科研抗体货号: P00678别名: sem2应用: WB,IHC反应种属: Human, Mouse

鄂公网安备42018502007531号
鄂公网安备42018502007531号

